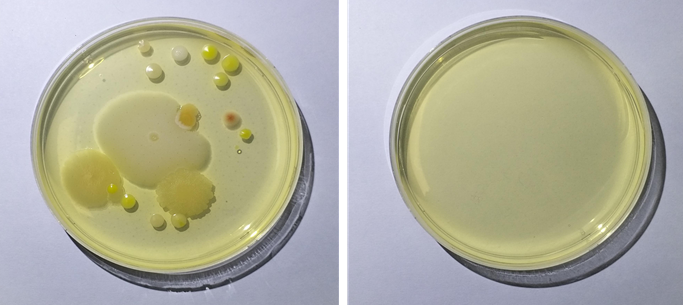

한국에너지기술연구원은 물의 정전분무*를 이용한 고효율의 공기청정 기술을 개발하고 실증 연구를 성공리에 마쳤다.
* 정전분무: 분무 시 노즐을 통과하는 액체에 양(+), 음(-)의 고전압을 공급함으로써 액체 속의 이온이 표면으로 이동하며 수십 마이크로미터 크기의 미세한 액적(물 덩어리)으로 변화되는 기술
초미세먼지, 부유세균, 휘발성 유기화합물 등 3-in-1 제거 성능 검증
지하철 역사 내 미세먼지의 농도는 대기에서 측정된 농도보다 1.5∼5배 정도 높게 측정되고 있어 보다 효율적인 미세먼지 저감 대책이 필요하다. 또한, 현재 곰팡이나 박테리아와 같은 부유 세균과 총 휘발성 유기화합물(TVOCs*) 농도에 관한 기준이 제시되어 있지 않지만, 요즘과 같은 코로나 시국에는 일상생활 속에서 불특정 다수의 이용객들이 바이러스, 세균 등에 노출될 수 있으므로 이에 대한 대응방안이 필요한 시점이다.
* TVOCs(Total Volatile Organic Compounds): 대기 중으로 쉽게 증발되는 액체 또는 기체상 유기화합물의 총칭(벤젠, 톨루엔, 에틸벤젠, 자일렌, 스티렌 등). 이들 휘발성 유기화합물은 대개의 경우 저농도에서도 악취를 유발하며, 화합물 자체로서도 환경 및 인체에 직접적으로 유해하거나 대기 중에서 광화학반응에 참여해 광화학산화물 등 2차 오염물질을 생성
이에 한국에너지기술연구원 EMS연구실 최종원 박사 연구진은 효과적인 공기질 관리를 위해 물에 고전압을 걸어 초미세먼지, 부유세균 및 휘발성 유기화합물을 3-in-1 으로 동시에 저감시킬 수 있는 정전 분무 방식의 차세대 공기청정 기술을 개발하고, 서울교통공사 5호선 장한평 역사 내에서 성공리에 실증 연구를 마쳐 주목을 받고 있다.
일반적으로 주사기 바늘에 물을 천천히 흐르게 하면 물방울은 표면장력에 의해 방울 방울 떨어지게 된다. 하지만 물이 흐르는 바늘에 고전압을 인가해주면 물 분자 사이의 전기적 척력에 의해 바늘 끝에서 높은 하전을 띈 수백만 개 이상의 작은 물 액적들이 서로 밀어내며 분사된다. 이를 정전분무라 하며, 실내 공기질을 관리하는데 있어 다양한 효과를 볼 수 있다.

먼저, 물방울 표면에 높은 밀도로 전자가 하전되어 있는 물 액적들은 주변을 지나가는 다수의 미세먼지들을 정전기적 인력으로 끌어와 미세먼지들끼리 응집시키며 제거할 수 있다. 기존의 물을 이용한 공기청정 기술은 미세먼지와 물이 직접 충돌해야만 미세먼지를 제거할 수 있었던 반면, 정전분무를 이용한 공기청정 기술은 직접 충돌과 정전기적 인력에 의한 간접충돌을 모두 이용할 수 있어 높은 효율로 미세먼지를 포집할 수 있게 된다. 연구진은 이 원리를 이용해 산업용 사이클론 집진기 내부에 정전분무 모듈을 삽입한 정전분무 사이클론으로 보령화력발전소 굴뚝 설비에 적용해 높은 집진 효율을 확인한 바 있다.
정전기적 인력, 수산화 이온 및 오존수의 산화를 이용한 차세대 공기청정 기술
일반적으로 물은 5~20 ㎛ 사이의 작은 크기가 되면 액적 표면이 자발적으로 수소 이온과 수산화 이온(OH╴)으로 나뉘게 된다. 이러한 작은 물 액적들이 바늘과 전극 사이에 형성되는 수 kV/cm의 높은 전기장 환경에 놓이면, 표면의 수산화 이온이 수산화 라디컬(OH⦁)로 변함과 동시에 2개의 수산화 라디컬이 결합해 소독약 성분인 과산화수소(H2O2)로 변한다. 또한, 노즐 주위를 지나는 공기 중에 있는 일부 산소 분자는 전기장을 지나면서 코로나 방전*에 의해 오존으로 산화됨과 동시에 물 액적 속에 용해되어 강력한 산화력·살균력을 지닌 오존수가 된다.
* 코로나 방전(Corona discharge): 도체 주위의 유체의 이온화로 인해 발생하는 전기적 방전
이렇게 생성된 과산화수소수와 오존수는 실내 공기 내 떠다니는 세균, 바이러스를 제거할 수 있을 뿐만 아니라 악취도 제거할 수 있는 가능성을 가지고 있다. 더 나아가 새집증후군을 일으키는 톨루엔, 아세트알데히드 등 휘발성 유기화합물들도 이산화탄소와 물로 분해할 수 있다.
지하철 플랫폼 내 실증으로 기술력 검증 및 적용 분야 다양화에 큰 기대
연구진은 이러한 원리를 이용하여 별도의 첨가제 없이 물만의 본질을 이용한 정전분무 기술로 초미세먼지의 집진, 부유세균의 살균, 휘발성 유기화합물의 산화가 동시에 이루어질 수 있는 공기청정기를 개발해 지하철 플랫폼에서 동시 저감 기술의 검증까지 마쳤다.

한편, 지하철 플랫폼의 경우 공기 오염의 원인이 외부에서 유입된 초미세먼지 외에도 역사로 진입하는 열차의 바퀴 및 철로의 마모를 통해 발생된 초미세 철 입자가 매우 큰 비중을 차지하고 있다. 즉, 지하철 플랫폼의 경우 초미세먼지를 구성하고 있는 주요 성분은 외부에서 유입된 탄소계열과 지하철 내부에서 발생한 산화철 계열 입자라고 할 수 있다.
연구진은 이러한 지하철 역사만의 특수한 환경을 고려하여 미세먼지의 물성 특성에 따른 맞춤형 집진 기술을 적용했다. 만일 정전분무를 이용한 집진 시 철 입자까지도 물로 포집한 후 그 물을 재순환시켜 이용하게 되면 부식에 의한 수질 오염의 우려가 있다. 이에 다수의 구리 코일을 공기청정기 입구에 배치해 코일 주변에 유도 자기장을 발생시켜 1차적으로 철 미세입자를 포집했으며, 2차적으로 고하전 물 액적에 의해 철 입자를 제외한 미세먼지를 포집했다.

이러한 프로세스를 거쳐 지하철 플랫폼 내에서 3-in-1 정전분무 공기청정기의 성능을 알아본 결과, PM2.5에 해당하는 초미세먼지는 최대 98%까지 제거할 수 있었으며, 30 CMM(m3/min) 규모 처리 능력이 있는 정전분무 공기청정기 2대를 연속 가동했을 때 역사의 플랫폼 공간 중 약 80평에 해당하는 면적의 미세먼지 농도를 최대 40%까지 감소시킬 수 있었다. 스크린 도어, 계단 등을 통해 외부로부터 끊임없이 미세먼지가 유입되는 반 밀폐된 구조의 지하철 플랫폼을 고려해보았을 때 이 수치는 상당히 높다고 볼 수 있다. 또한, 정전분무 시 생성되는 과산화수소수 및 오존수에 의해 총 부유세균은 99.9% 이상, 총 휘발성 유기화합물은 96% 이상 저감시키는 것을 확인했다.
전기를 이용한 공기청정기의 경우 가스상으로 배출되는 오존에 관해 엄격하게 규제를 하고 있다. 3-in-1 정전분무 공기청정기 출구에서 배출되는 공기 내 오존 농도를 정밀하게 측정해본 결과 법적 규제치인 0.05 ppm에 훨씬 못 미치는 0.015 ppm으로 측정됐다. 역사 내 공기청정기가 설치된 반대편 플랫폼의 공기 내에서 자연적으로 존재하는 오존의 농도가 0.01 ppm으로 측정된 걸 감안하면 공기청정기의 운전 중 생성된 오존이 물에 용해되지 않고 배출되는 양은 약 0.005 ppm 이하로 매우 낮은 것을 확인할 수 있다.
지하철역, 병원, 체육관 등 공공시설은 물론 가정용으로까지 확대 가능
연구진이 개발한 기술은 필터를 사용하지 않으므로 기존 여과식 공기청정기가 지니고 있는 높은 차압에 따른 팬 소모동력 증가 및 주기적인 필터의 교체비용에 대한 부담을 덜어줄 수 있다. 단순히 물의 보충 및 저가의 물필터의 교체가 유지보수의 전부인 편리한 실내 공기질 관리의 새로운 방법을 제시한 것이라서 경제적으로도 의미가 매우 높고 활용 범위도 넓어질 것으로 기대된다.
연구 책임자인 최종원 책임연구원은 “지하철, 지하상가 등 반밀폐형 공간의 실내 공기질을 관리하기 위해 집진, 살균, TVOCs 산화 설비를 각각 설치하는 것은 설치비용, 유지보수 비용 및 공간적 제약 등 소비자에게 큰 부담으로 느껴질 수 있기 때문에 물을 이용한 3-in-1 정전분무 기술이 대안이 될 수 있다.”고 말하며, “정전분무 공기청정 기술에 관한 연구는 이제 막 기초 성능에 관한 검증을 마친 상태로 시장에 진입하기 위해서 다양한 악취, 바이러스 등을 대상으로 성능 검증을 넓혀갈 계획이며, 기술이 상용화될 경우 불특정 다수가 이용하는 지하철, 어린이집, 학교, 병원, 백화점, 군부대, 종교시설 등과 같은 다중 이용시설의 경제적이고 효과적인 공기질 개선에 큰 도움을 줄 수 있을 것으로 판단된다.”고 말했다.
한편 이번 연구는 연구원 주요사업과 산업통상자원부 한국에너지기술평가원에서 지원하는 에너지기술개발사업의 일환으로 2017년부터 4년간 진행되고 있다.
- 사이언스타임즈
- 저작권자 2021-05-07 ⓒ ScienceTimes
관련기사

뉴스레터



